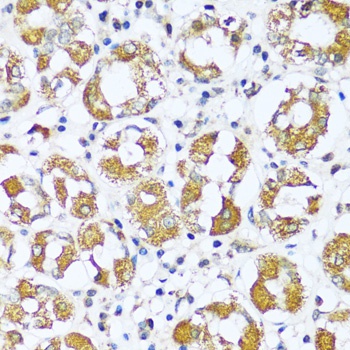
Product Image

Description
ATP5I Antibody (CAB16769)
The ATP5I Antibody (CAB16769) is a high-quality antibody developed for reliable detection and analysis of target proteins. This antibody is specifically designed for use in Western blot applications and is highly reactive with human samples. By binding to the ATP5I protein, this antibody enables the detection and analysis of ATP synthase activity in various cell types.ATP5I plays a crucial role in cellular energy production through the generation of ATP, the primary energy currency of the cell. Dysregulation of ATP5I has been implicated in various diseases, including metabolic disorders and neurodegenerative diseases.
This antibody is validated for use in WB, IHC-P, IF/ICC, ELISA applications and has demonstrated reactivity against Human, Mouse, Rat samples.
| Product Name: | ATP5I Antibody |
| SKU: | CAB16769 |
| Size: | 20μL, 100μL |
| Reactivity: | Human, Mouse, Rat |
| Immunogen: | Recombinant protein (or fragment).This information is considered to be commercially sensitive. | ||||||||
| Sequence: | MVPP VQVS PLIK LGRY SALF LGVA YGAT RYNY LKPR AEEE RRIA AEEK KKQD ELKR IARE LAED DSIL K | ||||||||
| Tested Applications: | WB IHC-P IF/ICC ELISA | ||||||||
| Recommended Dilution: |
| ||||||||
| Synonyms: | ATP5I, ATP5K |
| Positive Sample: | U-87MG, LO2, 293T, HeLa |
| Cellular Localization: | Mitochondrion, Mitochondrion Inner Membrane. |
| Calculated MW: | 8kDa |
| Observed MW: | Refertofigures |
Mitochondrial ATP synthase catalyzes ATP synthesis, utilizing an electrochemical gradient of protons across the inner membrane during oxidative phosphorylation. It is composed of two linked multi-subunit complexes: the soluble catalytic core, F1, and the membrane-spanning component, Fo, which comprises the proton channel. The F1 complex consists of 5 different subunits (alpha, beta, gamma, delta, and epsilon) assembled in a ratio of 3 alpha, 3 beta, and a single representative of the other 3. The Fo seems to have nine subunits (a, b, c, d, e, f, g, F6 and 8). This gene encodes the e subunit of the Fo complex. Alternative splicing results in multiple transcript variants.
| Purification Method | Affinity purification |
| Gene ID | 521 |
| RRID | AB_2768506 |
| Buffer Information | Store at -20℃. Avoid freeze / thaw cycles. Buffer: PBS with 0.01% thimerosal,50% glycerol,pH7.3. |